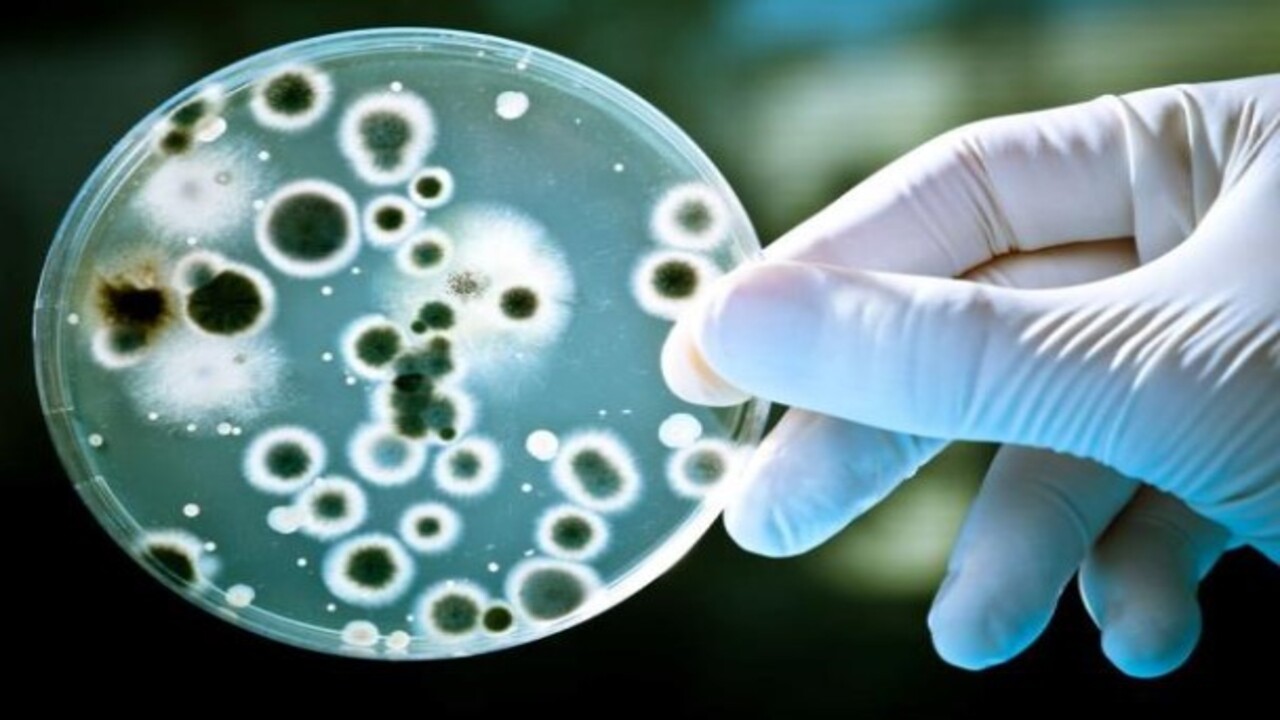
Foto - Uzmanlar özellikle uyardı! İşte evinize sessizce sızan tehlikeli bakteri

Uzmanlar özellikle uyardı! İşte evinize sessizce sızan tehlikeli bakteri
Uzmanlar, dışarıda kullanılan ayakkabıların ev ortamına ölümcül bakteriler ve kansere yol açabilecek kimyasallar taşıyabileceği konusunda vatandaşları uyardı.
Uzmanlar, dışarıda kullanılan ayakkabıların ev ortamına ölümcül bakteriler ve kansere yol açabilecek kimyasallar taşıyabileceği konusunda vatandaşları uyardı.
Westminster Üniversitesi?nden Mikrobiyolog Dr. Manal Mohammed, her dört ayakkabı çiftinden birinde, yaşamı tehdit eden böbrek hastalıklarına yol açabilecek toksik E. coli bakterisinin bulunduğunu söyledi. Dr. Mohammed, özellikle araba yolları ve kaldırımlarda kullanılan kanserojen dolgu maddelerinin de ev içerisine taşınabileceğini belirtti. Araştırmalar, bu zararlı maddelerin iç mekanlarda, dış ortama göre 37 kat daha yoğun şekilde bulunabileceğini ortaya koyuyor.
DailyMail'de yer alan habere göre uzman isim, ?Açık havada giyilen ayakkabılar bakteri, alerjen ve toksik kimyasallar taşıyor. Bunların çoğu ciddi sağlık sorunlarına yol açabilir,? ifadelerini kullandı. ?Dışarıda giyilen ayakkabılarla evde dolaşmak, sokaktaki her şeyi en mahrem yaşam alanlarınıza davet etmek gibidir.? Ayakkabıların gün içerisinde tuvalet zeminleri, hastane koridorları, parklar ve tarlalar gibi birçok kirli yüzeye temas ettiğini belirten uzman, bu durumun özellikle evde emekleyen küçük çocuklar için büyük bir sağlık riski oluşturduğunu söyledi.
EVDE TEHLİKE SAÇIYOR E. coli, hayvan ve insan dışkısında doğal olarak bulunan bir bakteri türü. Ancak bazı türleri, kanlı ishale ve ölümcül olabilen hemolitik üremik sendroma (HÜS) neden olabiliyor. Geçtiğimiz yıl İngiltere'de bazı süpermarketlerde satılan kirli sandviçlerle ilişkilendirilen E. coli salgını, iki kişinin ölümüne ve yüzlerce kişinin hastaneye kaldırılmasına neden olmuştu. Diğer araştırmalar, ayakkabıların ayrıca ishale yol açabilen Clostridium difficile ve ağrılı cilt enfeksiyonlarına neden olan stafilokok gibi mikropları da taşıyabildiğini gösteriyor.
Dr. Mohammed, ayakkabılarla ev içerisinde dolaşmanın bir başka riskini de kurşun tozu olarak tanımlıyor. Beyin gelişimini olumsuz etkileyen bu ağır metal, özellikle küçük çocuklar için büyük tehlike oluşturuyor. Polen gibi alerjenlerin de ayakkabılara yapışarak eve taşınabildiğini belirten uzman, saman nezlesi gibi rahatsızlıkları olan kişilerde bu durumun alerjik reaksiyonları artırabileceği uyarısında bulundu.
AYAKKABILARI EVDE ÇIKARMAK: BASİT AMA ETKİLİ BİR YÖNTEM Dr. Mohammed, dışarıda kullanılan ayakkabıların evde çıkarılmasının, halk sağlığı açısından alınabilecek en basit ve en etkili önlemlerden biri olduğunu vurguladı. 'Bu küçük alışkanlık, ailenizi zararlı mikroplardan ve kimyasallardan korumada büyük fark oluşturabilir' dedi. Ancak bazı uzmanlar, ayakkabıların içeride giyilmesinin bağışıklık sistemi açısından olumlu etkileri olabileceğini savunuyor. 2019 yılında Finlandiya?da yapılan bir araştırma, evde ayakkabı çıkarılmayan hanelerde yaşayan çocuklarda astım görülme oranının daha düşük olduğunu ortaya koydu.
Bu görüş, "hijyen hipotezi" olarak bilinen ve modern yaşamın aşırı steril olması nedeniyle bağışıklık sisteminin yeterince gelişemediğini öne süren teoriye dayanıyor. Buna göre, erken yaşlarda kir ve mikroplarla temas etmeyen çocukların bağışıklık sistemleri toz ve polen gibi maddelere karşı aşırı tepkiler geliştirebiliyor. Ancak bu hipotezin bilimsel geçerliliği hâlâ tartışma konusu olmaya devam ediyor.
WhatsApp İhbar Hattı
+90 (553) 313 94 23